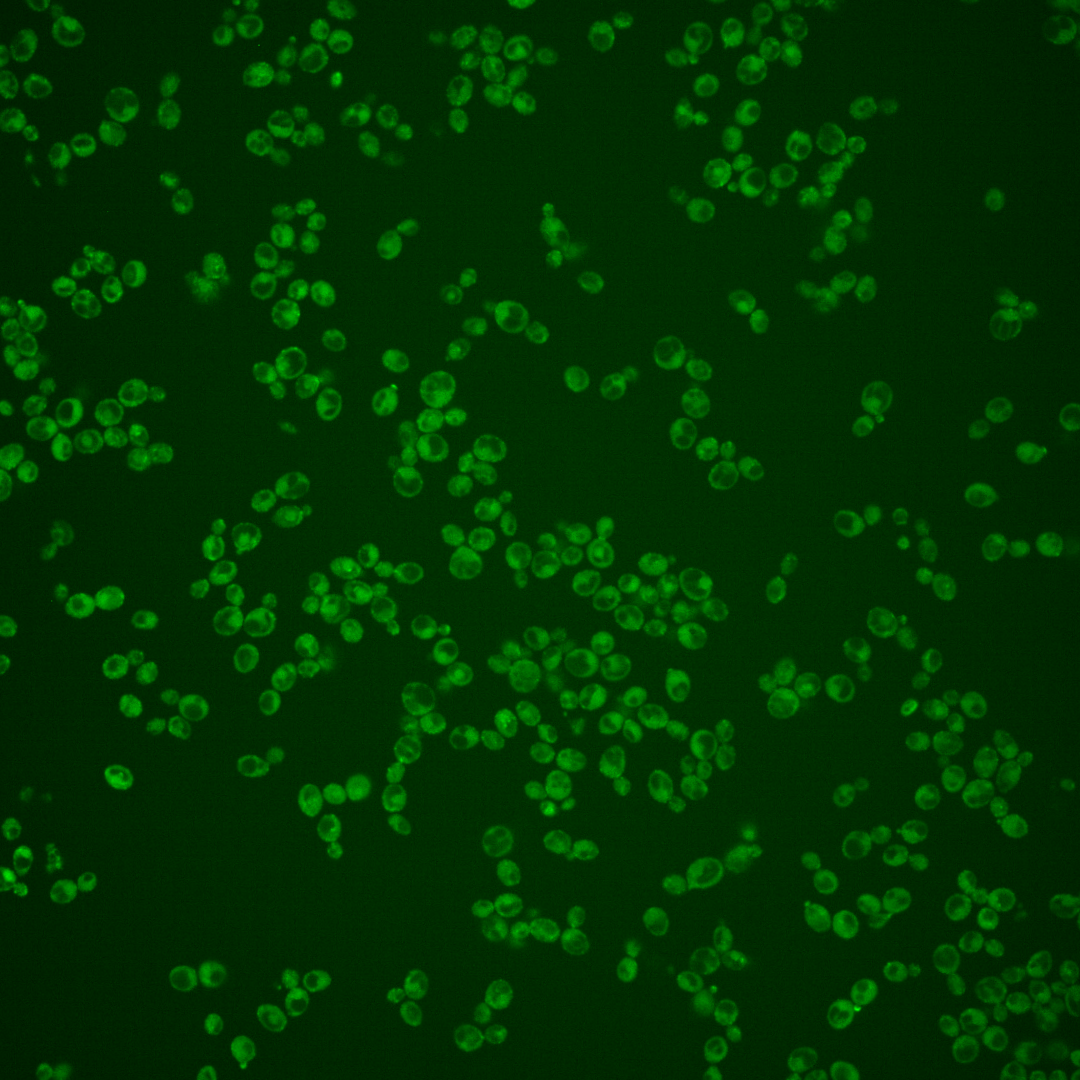
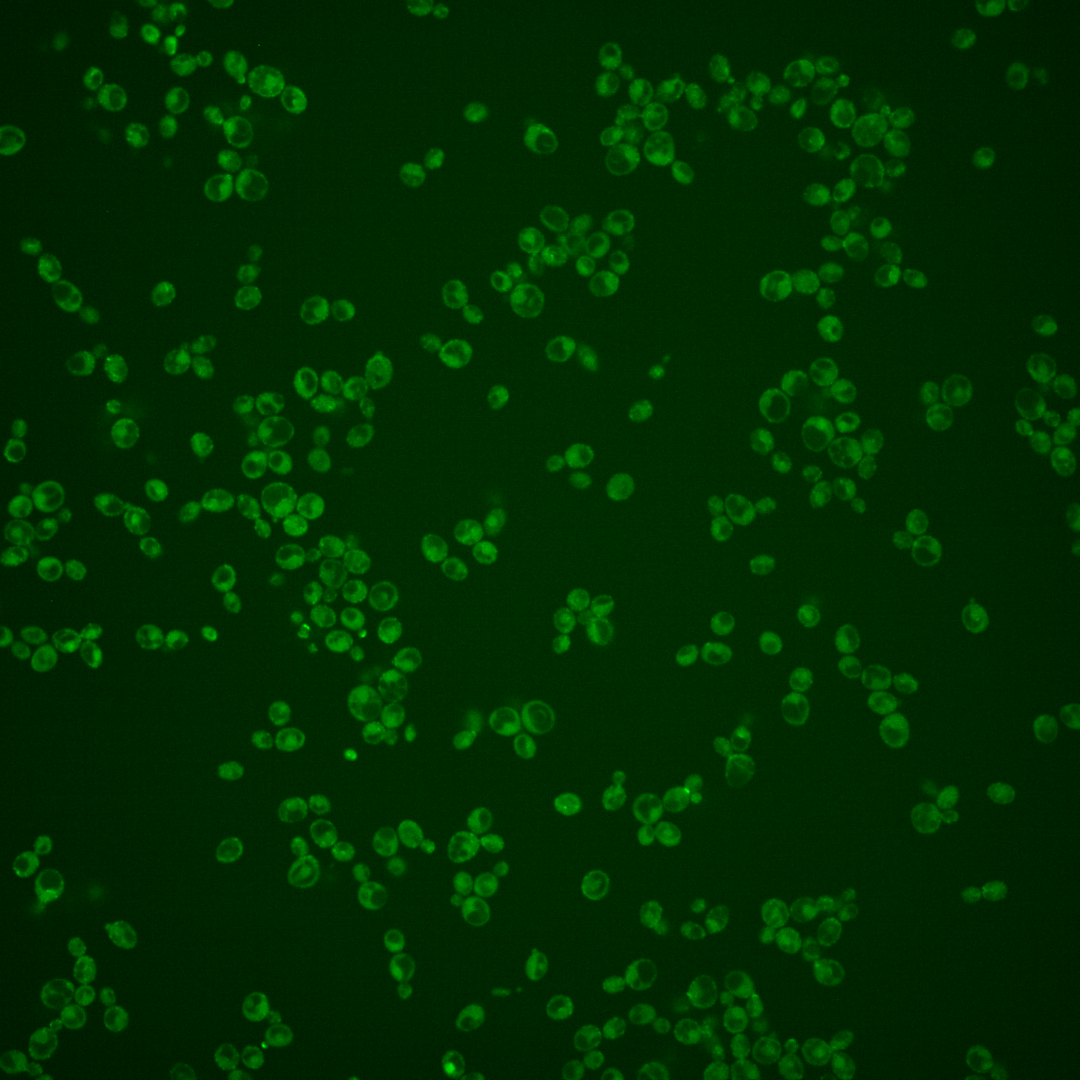
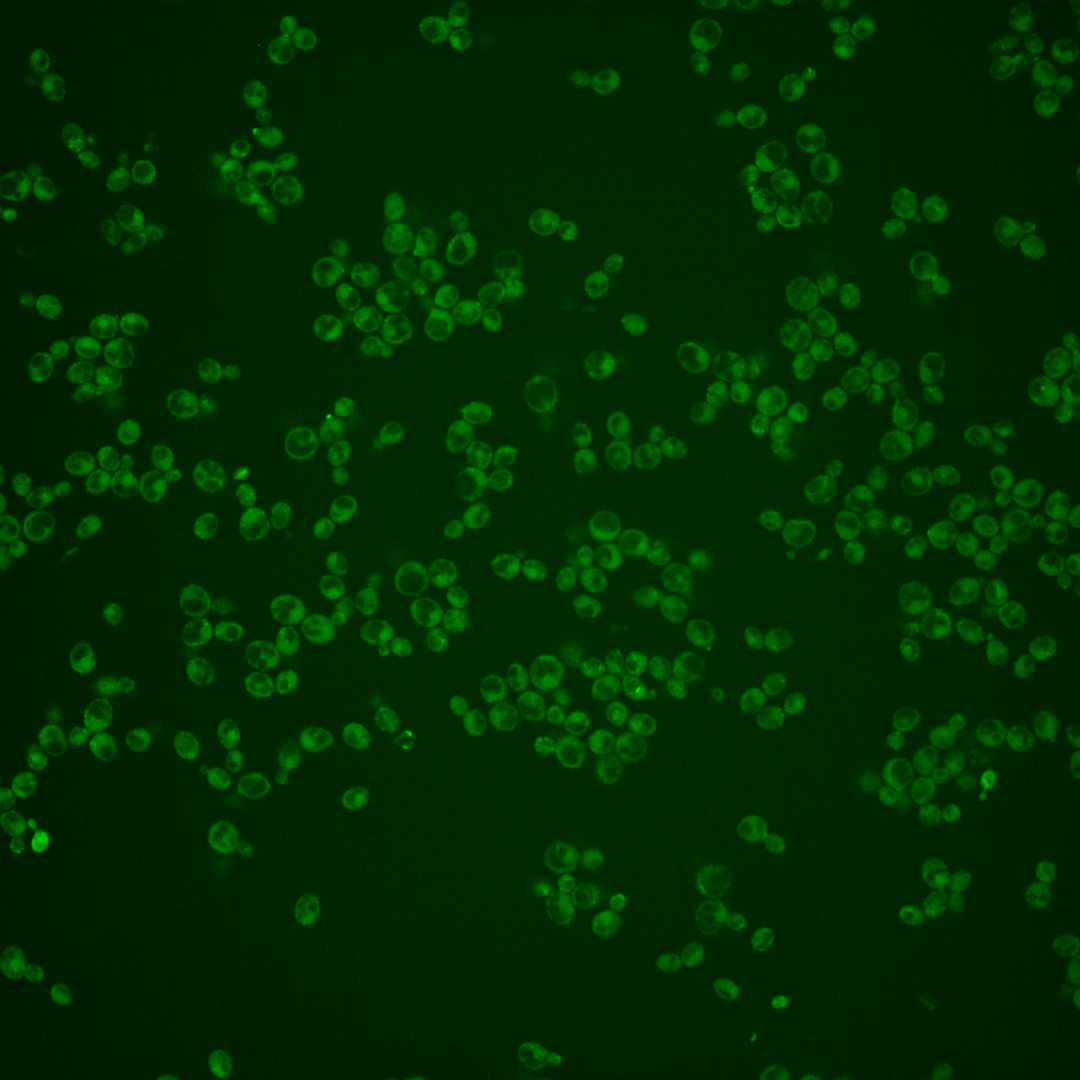
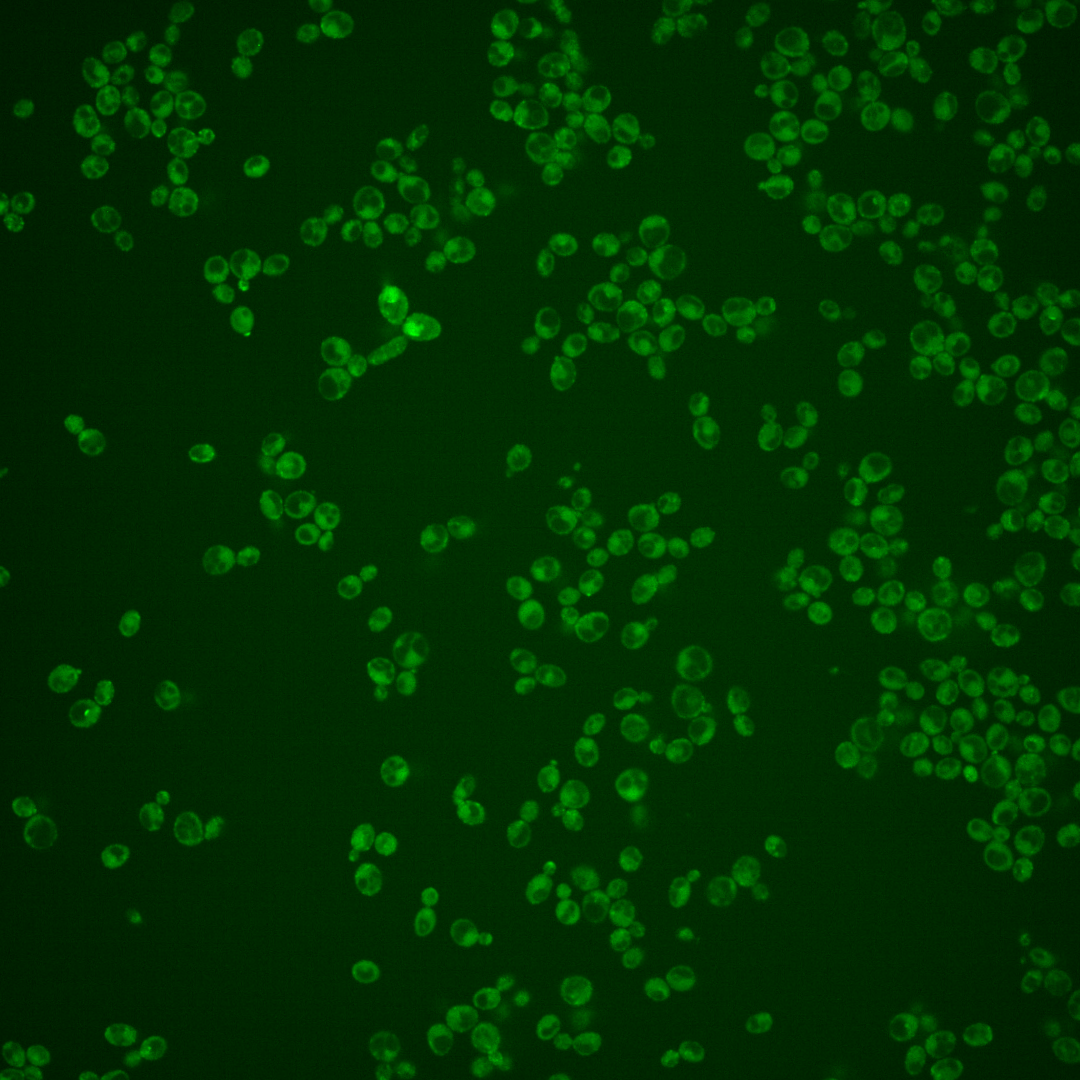
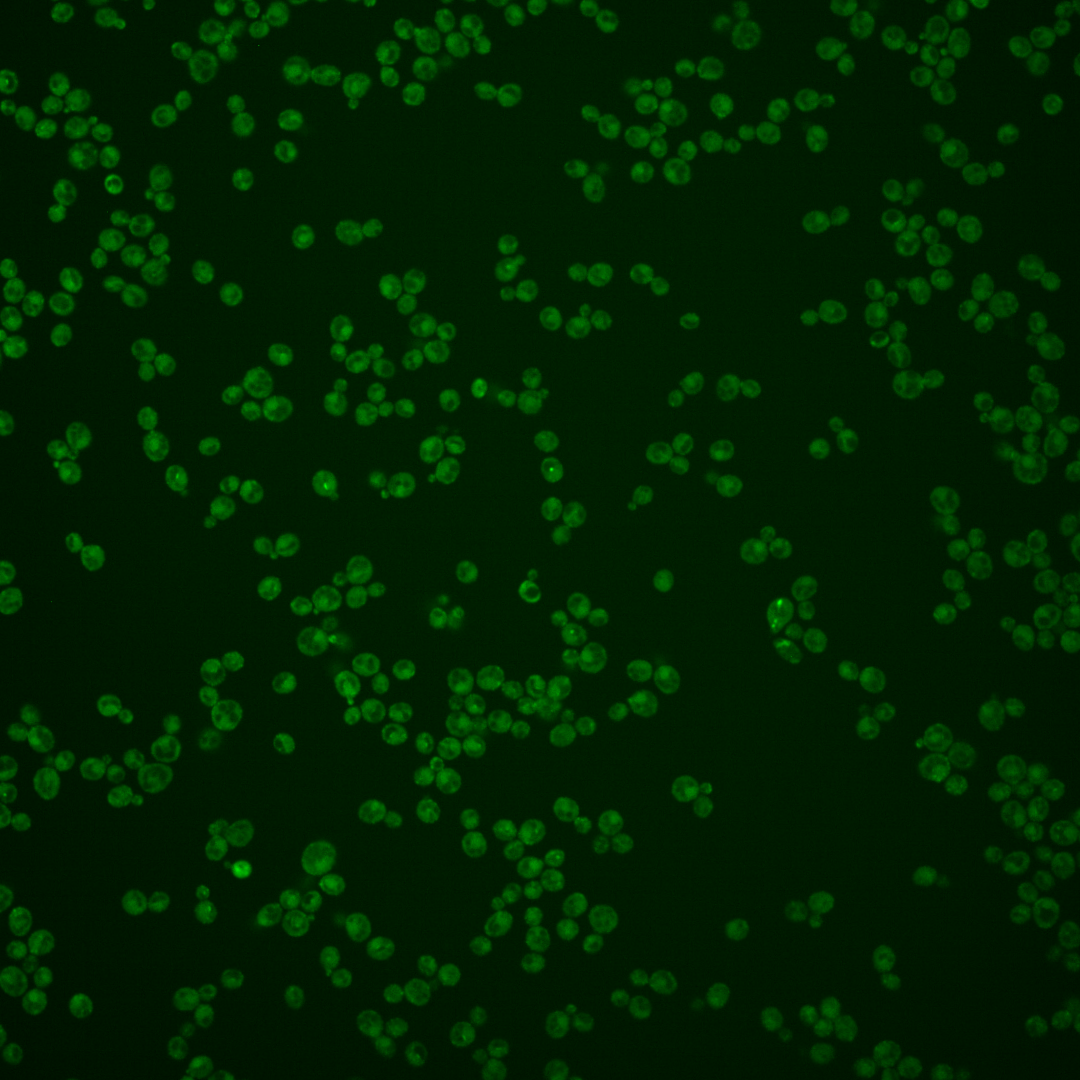

| Standard name | |
|---|---|
| Human Ortholog | |
| Description | ER-resident protein involved in peroxisomal biogenesis; ER-localized protein that associates with peroxisomes; interacts with Pex30p and reticulons Rtn1p and Yop1p to regulate peroxisome biogenesis from the ER; role in peroxisomal-destined vesicular flow from the ER; regulates peroxisomal size, number and distribution; Pex28p and Pex29p may act at steps upstream of those mediated by Pex30p, Pex31p, and Pex32p; forms ER foci upon DNA replication stress |
Micrographs




















































































Sub-cellular Localization
Yeast GFP Assignment
Protein Abundance
Localization Change
External localization resources
| ensLOC | DeepLoc | |||||||||||||||||||||||
|---|---|---|---|---|---|---|---|---|---|---|---|---|---|---|---|---|---|---|---|---|---|---|---|---|
| Localization | WT1 | WT2 | WT3 | RAP60 | RAP140 | RAP220 | RAP300 | RAP380 | RAP460 | RAP540 | RAP620 | RAP700 | HU80 | HU120 | HU160 | rpd3Δ_1 | rpd3Δ_2 | rpd3Δ_3 | WT1 | WT2 | WT3 | AF100 | AF140 | AF180 |
| Cortical Patches | 41 | 37 | – | 35 | 51 | 52 | 77 | 67 | 24 | 42 | 44 | 37 | 48 | 95 | 109 | 85 | 105 | 130 | 40 | 37 | 9 | 15 | 87 | 120 |
| Bud | 12 | 5 | – | 7 | 10 | 15 | 32 | 30 | 20 | 36 | 41 | 42 | 10 | 23 | 10 | 12 | 31 | 33 | 3 | 2 | 2 | 5 | 13 | 20 |
| Bud Neck | 0 | 1 | – | 1 | 7 | 1 | 2 | 2 | 1 | 1 | 1 | 0 | 3 | 10 | 3 | 0 | 12 | 0 | 3 | 9 | 3 | 7 | 34 | 36 |
| Bud Site | 0 | 0 | – | 0 | 0 | 0 | 0 | 0 | 2 | 1 | 0 | 2 | 0 | 0 | 0 | 1 | 0 | 2 | – | – | – | – | – | – |
| Cell Periphery | 4 | 14 | – | 17 | 40 | 35 | 27 | 19 | 9 | 11 | 11 | 17 | 24 | 63 | 88 | 40 | 78 | 56 | 5 | 11 | 4 | 7 | 51 | 86 |
| Cytoplasm | 32 | 56 | – | 114 | 134 | 170 | 239 | 208 | 113 | 141 | 130 | 208 | 267 | 411 | 516 | 39 | 43 | 95 | 9 | 22 | 2 | 16 | 53 | 69 |
| Endoplasmic Reticulum | 51 | 82 | – | 33 | 64 | 87 | 173 | 125 | 53 | 63 | 69 | 58 | 61 | 75 | 174 | 10 | 19 | 20 | 56 | 74 | 10 | 27 | 100 | 186 |
| Endosome | 4 | 0 | – | 3 | 0 | 6 | 9 | 12 | 12 | 15 | 2 | 18 | 1 | 4 | 16 | 3 | 5 | 11 | 7 | 7 | 2 | 2 | 9 | 5 |
| Golgi | 0 | 0 | – | 2 | 1 | 0 | 0 | 0 | 0 | 0 | 0 | 0 | 0 | 1 | 1 | 9 | 10 | 5 | 4 | 4 | 0 | 1 | 1 | 1 |
| Mitochondria | 33 | 4 | – | 5 | 6 | 62 | 153 | 84 | 110 | 160 | 269 | 272 | 0 | 6 | 1 | 18 | 20 | 35 | 26 | 32 | 16 | 26 | 56 | 50 |
| Nucleus | 0 | 2 | – | 0 | 1 | 0 | 8 | 6 | 6 | 3 | 1 | 3 | 1 | 3 | 4 | 3 | 5 | 7 | 0 | 1 | 0 | 1 | 2 | 2 |
| Nuclear Periphery | 0 | 0 | – | 0 | 0 | 0 | 0 | 0 | 0 | 1 | 0 | 1 | 0 | 0 | 0 | 0 | 0 | 0 | 0 | 0 | 0 | 1 | 1 | 0 |
| Nucleolus | 0 | 0 | – | 0 | 0 | 1 | 0 | 0 | 0 | 0 | 0 | 0 | 0 | 0 | 0 | 0 | 0 | 0 | 0 | 0 | 0 | 0 | 0 | 0 |
| Peroxisomes | 0 | 0 | – | 0 | 0 | 0 | 1 | 0 | 0 | 2 | 0 | 1 | 0 | 3 | 0 | 1 | 10 | 7 | 2 | 0 | 0 | 0 | 0 | 0 |
| SpindlePole | 3 | 1 | – | 3 | 4 | 2 | 10 | 12 | 2 | 3 | 2 | 7 | 6 | 10 | 46 | 13 | 16 | 18 | 0 | 0 | 0 | 0 | 2 | 0 |
| Vac/Vac Membrane | 1 | 0 | – | 0 | 0 | 7 | 18 | 23 | 20 | 20 | 26 | 42 | 2 | 4 | 16 | 7 | 11 | 11 | 14 | 25 | 5 | 14 | 34 | 43 |
| Unique Cell Count | 130 | 181 | 185 | 263 | 349 | 612 | 501 | 301 | 406 | 469 | 580 | 368 | 601 | 849 | 183 | 267 | 325 | 176 | 234 | 62 | 132 | 456 | 633 | |
| Labelled Cell Count | 181 | 202 | 220 | 318 | 438 | 749 | 588 | 372 | 499 | 596 | 708 | 423 | 708 | 984 | 241 | 365 | 430 | 176 | 234 | 62 | 132 | 456 | 633 | |
Yeast GFP Assignment
Protein Abundance
| Screen | WT1 | WT2 | WT3 | RAP60 | RAP140 | RAP220 | RAP300 | RAP380 | RAP460 | RAP540 | RAP620 | RAP700 | HU80 | HU120 | HU160 | rpd3Δ_1 | rpd3Δ_2 | rpd3Δ_3 | AF100 | AF140 | AF180 |
|---|---|---|---|---|---|---|---|---|---|---|---|---|---|---|---|---|---|---|---|---|---|
| Mean Cell GFP Intensity (1e-4) | 5.0 | 6.3 | – | 6.1 | 6.3 | 5.7 | 5.7 | 6.0 | 5.3 | 5.4 | 5.0 | 5.2 | 7.0 | 6.7 | 7.5 | 8.7 | 8.6 | 7.5 | 6.4 | 6.9 | 7.3 |
| Std Deviation (1e-4) | 0.6 | 0.9 | – | 1.2 | 0.9 | 1.0 | 1.0 | 0.9 | 0.9 | 0.8 | 0.9 | 0.8 | 1.2 | 1.3 | 1.2 | 1.5 | 1.5 | 1.5 | 1.5 | 1.6 | 1.4 |
| Intensity Change (Log2) | – | – | – | – | – | – | – | – | – | – | – | – | – | – | – | – | – | – | – | – | – |
Localization Change
| Localization | RAP60 | RAP140 | RAP220 | RAP300 | RAP380 | RAP460 | RAP540 | RAP620 | RAP700 | HU80 | HU120 | HU160 | rpd3Δ_1 | rpd3Δ_2 | rpd3Δ_3 |
|---|---|---|---|---|---|---|---|---|---|---|---|---|---|---|---|
| Actin | – | – | – | – | – | – | – | – | – | – | – | – | – | – | – |
| Bud | – | – | – | – | – | – | – | – | – | – | – | – | – | – | – |
| Bud Neck | – | – | – | – | – | – | – | – | – | – | – | – | – | – | – |
| Bud Site | – | – | – | – | – | – | – | – | – | – | – | – | – | – | – |
| Cell Periphery | – | – | – | – | – | – | – | – | – | – | – | – | – | – | – |
| Cyto | – | – | – | – | – | – | – | – | – | – | – | – | – | – | – |
| Endoplasmic Reticulum | – | – | – | – | – | – | – | – | – | – | – | – | – | – | – |
| Endosome | – | – | – | – | – | – | – | – | – | – | – | – | – | – | – |
| Golgi | – | – | – | – | – | – | – | – | – | – | – | – | – | – | – |
| Mitochondria | – | – | – | – | – | – | – | – | – | – | – | – | – | – | – |
| Nuclear Periphery | – | – | – | – | – | – | – | – | – | – | – | – | – | – | – |
| Nuc | – | – | – | – | – | – | – | – | – | – | – | – | – | – | – |
| Nucleolus | – | – | – | – | – | – | – | – | – | – | – | – | – | – | – |
| Peroxisomes | – | – | – | – | – | – | – | – | – | – | – | – | – | – | – |
| SpindlePole | – | – | – | – | – | – | – | – | – | – | – | – | – | – | – |
| Vac | – | – | – | – | – | – | – | – | – | – | – | – | – | – | – |
| Cortical Patches | – | – | – | – | – | – | – | – | – | – | – | – | – | – | – |
| Cytoplasm | – | – | – | – | – | – | – | – | – | – | – | – | – | – | – |
| Nucleus | – | – | – | – | – | – | – | – | – | – | – | – | – | – | – |
| Vacuole | – | – | – | – | – | – | – | – | – | – | – | – | – | – | – |
External localization resources
Images






























Protein Concentration and Protein Localization Data
| R1 | R2 | R3 | ||||||||||||||||
|---|---|---|---|---|---|---|---|---|---|---|---|---|---|---|---|---|---|---|
| G1 Pre-START | G1 Post-START | S/G2 | Metaphase | Anaphase | Telophase | G1 Pre-START | G1 Post-START | S/G2 | Metaphase | Anaphase | Telophase | G1 Pre-START | G1 Post-START | S/G2 | Metaphase | Anaphase | Telophase | |
| Concentration | 2.7475 | 2.3822 | 2.663 | 2.7865 | 2.5666 | 2.4159 | 2.575 | 2.3274 | 2.5798 | 2.5075 | 2.1892 | 2.1924 | 0.4864 | 0.7499 | 0.83 | 0.6962 | 0.2265 | 0.9039 |
| Actin | 0.0594 | 0.0392 | 0.0608 | 0.0499 | 0.0439 | 0.031 | 0.1323 | 0.0626 | 0.171 | 0.0735 | 0.0396 | 0.1013 | 0.1304 | 0.0397 | 0.1444 | 0.1777 | 0.0442 | 0.0554 |
| Bud | 0.0059 | 0.0039 | 0.0245 | 0.0052 | 0.0028 | 0.0051 | 0.001 | 0.0016 | 0.04 | 0.0049 | 0.0007 | 0.0013 | 0.005 | 0.0079 | 0.0427 | 0.0085 | 0.0077 | 0.001 |
| Bud Neck | 0.0268 | 0.0047 | 0.0131 | 0.0302 | 0.051 | 0.0825 | 0.0089 | 0.0052 | 0.0073 | 0.0051 | 0.0023 | 0.1374 | 0.0163 | 0.0051 | 0.0104 | 0.0181 | 0.0012 | 0.1246 |
| Bud Periphery | 0.0165 | 0.0084 | 0.1014 | 0.0302 | 0.0094 | 0.0149 | 0.0017 | 0.0045 | 0.1385 | 0.0276 | 0.0022 | 0.0047 | 0.0094 | 0.005 | 0.1306 | 0.0537 | 0.0965 | 0.0036 |
| Bud Site | 0.0361 | 0.0822 | 0.0838 | 0.0044 | 0.0219 | 0.0071 | 0.0269 | 0.0974 | 0.0528 | 0.01 | 0.0012 | 0.0035 | 0.0375 | 0.1306 | 0.0658 | 0.0037 | 0.0009 | 0.0021 |
| Cell Periphery | 0.0225 | 0.0227 | 0.0209 | 0.0096 | 0.0125 | 0.0118 | 0.0222 | 0.0378 | 0.0335 | 0.0434 | 0.0101 | 0.0187 | 0.0211 | 0.0146 | 0.0153 | 0.0135 | 0.0051 | 0.012 |
| Cytoplasm | 0.3181 | 0.4394 | 0.3286 | 0.4728 | 0.4899 | 0.4626 | 0.419 | 0.4293 | 0.3342 | 0.4671 | 0.6403 | 0.5019 | 0.3835 | 0.4675 | 0.3143 | 0.3988 | 0.3517 | 0.5305 |
| Cytoplasmic Foci | 0.0895 | 0.0417 | 0.0396 | 0.026 | 0.0299 | 0.0653 | 0.0497 | 0.0567 | 0.0214 | 0.049 | 0.029 | 0.0309 | 0.0631 | 0.0437 | 0.0299 | 0.0509 | 0.0291 | 0.0366 |
| Eisosomes | 0.003 | 0.0025 | 0.0021 | 0.0008 | 0.0014 | 0.0008 | 0.002 | 0.0018 | 0.001 | 0.0012 | 0.0005 | 0.0012 | 0.002 | 0.0009 | 0.0016 | 0.0011 | 0.0007 | 0.001 |
| Endoplasmic Reticulum | 0.0549 | 0.069 | 0.058 | 0.0819 | 0.0821 | 0.0573 | 0.1027 | 0.0794 | 0.0398 | 0.1468 | 0.1159 | 0.0681 | 0.0767 | 0.0994 | 0.0657 | 0.0644 | 0.0762 | 0.1031 |
| Endosome | 0.0664 | 0.0432 | 0.0611 | 0.0651 | 0.035 | 0.0618 | 0.0798 | 0.0173 | 0.0241 | 0.032 | 0.0458 | 0.0279 | 0.0677 | 0.0241 | 0.033 | 0.0266 | 0.0598 | 0.0258 |
| Golgi | 0.0318 | 0.0224 | 0.0333 | 0.0133 | 0.0273 | 0.0328 | 0.0305 | 0.0167 | 0.0342 | 0.0316 | 0.0409 | 0.0185 | 0.0345 | 0.0166 | 0.0213 | 0.0421 | 0.0255 | 0.0254 |
| Lipid Particles | 0.0397 | 0.024 | 0.0127 | 0.0097 | 0.0055 | 0.0198 | 0.0297 | 0.0274 | 0.0071 | 0.0524 | 0.027 | 0.0108 | 0.0511 | 0.0319 | 0.0098 | 0.0128 | 0.0046 | 0.0087 |
| Mitochondria | 0.0181 | 0.0097 | 0.0337 | 0.1333 | 0.0279 | 0.0157 | 0.0053 | 0.0016 | 0.0061 | 0.0188 | 0.0044 | 0.0022 | 0.0066 | 0.0014 | 0.0052 | 0.0027 | 0.0018 | 0.0041 |
| None | 0.1384 | 0.1631 | 0.0814 | 0.028 | 0.1222 | 0.0942 | 0.0257 | 0.146 | 0.0732 | 0.0097 | 0.0189 | 0.0615 | 0.0453 | 0.096 | 0.0841 | 0.1164 | 0.2843 | 0.0582 |
| Nuclear Periphery | 0.0105 | 0.004 | 0.0038 | 0.0042 | 0.0084 | 0.0031 | 0.0103 | 0.0021 | 0.0025 | 0.0023 | 0.003 | 0.0012 | 0.0039 | 0.0028 | 0.0064 | 0.0016 | 0.0022 | 0.0013 |
| Nucleolus | 0.0053 | 0.0008 | 0.0013 | 0.0006 | 0.0021 | 0.0011 | 0.0029 | 0.0005 | 0.0003 | 0.0003 | 0.0002 | 0.0002 | 0.0117 | 0.0005 | 0.0011 | 0.0001 | 0.0003 | 0.0001 |
| Nucleus | 0.0084 | 0.0034 | 0.0043 | 0.0028 | 0.0072 | 0.003 | 0.014 | 0.0013 | 0.0013 | 0.0009 | 0.0008 | 0.0009 | 0.006 | 0.0016 | 0.0028 | 0.0007 | 0.0012 | 0.0009 |
| Peroxisomes | 0.0209 | 0.0027 | 0.0061 | 0.0065 | 0.0014 | 0.011 | 0.0158 | 0.0019 | 0.0017 | 0.0146 | 0.0092 | 0.0007 | 0.0123 | 0.0016 | 0.0027 | 0.0012 | 0.0003 | 0.0008 |
| Punctate Nuclear | 0.0066 | 0.002 | 0.0017 | 0.0007 | 0.0014 | 0.0065 | 0.0057 | 0.003 | 0.0008 | 0.0009 | 0.002 | 0.0006 | 0.0031 | 0.0031 | 0.0033 | 0.0009 | 0.0017 | 0.0008 |
| Vacuole | 0.0185 | 0.0099 | 0.0245 | 0.0166 | 0.0139 | 0.0106 | 0.0113 | 0.0058 | 0.0081 | 0.0069 | 0.005 | 0.006 | 0.0105 | 0.0055 | 0.0085 | 0.0037 | 0.0041 | 0.0035 |
| Vacuole Periphery | 0.0027 | 0.0011 | 0.0033 | 0.0081 | 0.003 | 0.0021 | 0.0027 | 0.0003 | 0.001 | 0.0009 | 0.0007 | 0.0007 | 0.002 | 0.0004 | 0.0013 | 0.0006 | 0.0009 | 0.0006 |
Sequencing Data
| R1 | R2 | |||||||||
|---|---|---|---|---|---|---|---|---|---|---|
| G1 Post-START | S/G2 | Metaphase | Anaphase | Telophase | G1 Post-START | S/G2 | Metaphase | Anaphase | Telophase | |
| Gene Expression | 8.6152 | 6.5166 | 5.2752 | 12.116 | 9.4515 | 13.9091 | 14.3758 | 16.3733 | 18.0431 | 14.4102 |
| Translational Efficiency | 0.8374 | 0.9216 | 1.3232 | 0.5449 | 0.6578 | 0.7403 | 0.5882 | 0.5561 | 0.583 | 0.6348 |
Hit Data
| Dataset | Hit |
|---|---|
| Protein Concentration | ✘ |
| Protein Localization | ✔ |
| Gene Expression | ✘ |
| Translational Efficiency | ✘ |
Endocytosis
| Temp | Actin Patch (Sac6-tdTomato) | Cortical Patch (Sla1-GFP) | Late Endosome (Snf7-GFP) | Vacuole (Vph1-GFP) |
|---|---|---|---|---|
| 37℃ | ||||
| RT |
Cell Cycle Omics
CYCLoPs (Pex29-GFP)
| Gene / Allele | Actin Patch (Sac6-tdTomato) | Cortical Patch (Sla1-GFP) | Late Endosome (Snf7-GFP) | Vacuole (Sac6-tdTomato) |
|---|
| Gene | Images |
|---|
| Gene | Images |
|---|
Images are not yet available
Images are not yet available